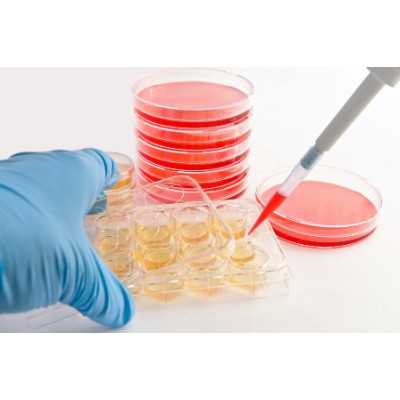
Сахарный диабет излечим с помощью стволовых клеток

Сахарный диабет излечим с помощью стволовых клеток
Проведенные недавно исследования открыли новые возможности успешной терапии сахарного диабета ІІ типа путем имплантации стволовых клеток. Во всяком случае, проведенные на мышах опыты увенчались успехом.
Подопытные животные были разделены на две группы. При этом, в обоих случаях, мыши уже имели вышеупомянутое заболевание и режим их питания был достаточно калорийным. В первом случае для терапии заболевания применялись традиционные медикаментозные препараты. Во втором случае, кроме таких препаратов, была произведена имплантация стволовых клеток, в точности повторяющих структуру клеток поджелудочной железы человека. В результате, группа животных с имплантированными стволовыми клетками резко снизила вес. Кроме того, развитие заболевание было в значительной мере приостановлено. В состоянии второй группы мышей не было отмечено никаких существенных изменений.
Результаты этих опытов станут основой для дальнейших исследований возможности использования стволовых клеток для лечения сахарного диабета ІІ типа.
Самые доступные цены на товары для диабетиков вы всегда сможете найти в интернет-магазине Дом Медтехники.
